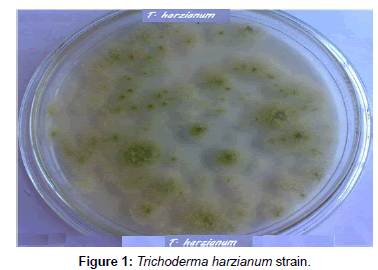

Indexed In
- Open J Gate
- Genamics JournalSeek
- Academic Keys
- JournalTOCs
- CiteFactor
- Ulrich's Periodicals Directory
- Access to Global Online Research in Agriculture (AGORA)
- Electronic Journals Library
- Centre for Agriculture and Biosciences International (CABI)
- RefSeek
- Directory of Research Journal Indexing (DRJI)
- Hamdard University
- EBSCO A-Z
- OCLC- WorldCat
- Scholarsteer
- SWB online catalog
- Virtual Library of Biology (vifabio)
- Publons
- Geneva Foundation for Medical Education and Research
- Euro Pub
- Google Scholar
Useful Links
Share This Page
Journal Flyer

Open Access Journals
- Agri and Aquaculture
- Biochemistry
- Bioinformatics & Systems Biology
- Business & Management
- Chemistry
- Clinical Sciences
- Engineering
- Food & Nutrition
- General Science
- Genetics & Molecular Biology
- Immunology & Microbiology
- Medical Sciences
- Neuroscience & Psychology
- Nursing & Health Care
- Pharmaceutical Sciences
Research Article - (2013) Volume 4, Issue 9
Stimulating of Biodegradation of Oxamyl Pesticide by Low Dose Gamma Irradiated Fungi
Abstract
This investigation has been conducted to study the possibility of stimulating Trichoderma spp with low dose gamma radiation for biodegradation of Oxamyl pesticides. Fungi strains capable for biodegradation of oxamyl are identified as Trichoderma spp., including T. harzianum, T. viride, Aspergillus niger, Fusarium oxysporum and Penicillium cyclopium. The results indicated that Trichoderma spp. used Oxamyl as source of carbon and nitrogen and possesses enzyme(s), which acts on amide and ester bond in Oxamyl structure. Degradation of oxamyl was 72.5% within 10 days of incubation by T. harzianum strain. It is very important to note that degradation of oxamyl 82.05% within 10 days of incubation by T. viride strain. This indicated that the isolates of Trichoderma spp. were potentially useful for oxamyl bioremediation. The biomass of Trichoderma spp strain were increased and reached its maximum at 250 Gy by 21.97 and 40.0 when using Trichoderma spp., as well as T. viride, respectively. As a general trends the gamma radiation over than 0.25 KGr reduce the growth of Trichoderma spp by 50.27 and 38.13, using Trichoderma spp. as well as T. viride, respectively.
Keywords: Oxamyl; Trichoderma harzianum; Trichoderma viride; Biodegradation; Gamma-irradiation
Introduction
Contamination of surface water by organophosphate and carbamate compounds is of concern because of the potential toxicity to aquatic organisms, especially those at lower trophic levels. Many organophosphate and carbamate compounds have acute and chronic toxicity to fish and aquatic invertebrates. Trichoderma spp strain improvement usually by exposing the microorganism to radiation that produces the enzyme by techniques, such as classical mutagenesis, which involves γ-rays, UV-rays [1].
Pesticides must persist long enough to control biological targets, but should not become a pollution problem [2,3]. Environmental of Oral and dermal exposure of rats to Pesticide cyanophos was characterized by studying acetylcholine esterase, aspartate transaminase, alanine transaminase and alkaline phosphatase (ALP) enzyme activities were studied by Afify and El-Beltagi [4], as biomarker for pesticides pollution. The toxicity of some pesticides, such as organophosphates and carbamate insecticides, is mainly caused by the inhibition of ChE activity of vertebrates and invertebrates. This inhibition leads to the accumulation of acetylcholine in the synaptic terminals, and therefore, to a change in the normal transmission of the nervous impulse. This interference may result in neurological manifestations, such as irritability, restlessness, muscular twitching and convulsions that may end in the respiratory failure and death of the animal [5]. Oxamyl and carbofuran, a broad-spectrum carbamate pesticide, has been used extensively in agriculture as a soil-incorporated to control a variety of insect pests of crops, including canola, corn, alfalfa, potatoes and strawberries [6]. Studies on microbial degradation are useful in the development of bioremediation strategies for the detoxification of these insecticides by microorganisms. Bioremediation is defined as the process, whereby organic wastes are biologically degraded under controlled conditions to an innocuous state, or to levels below concentration limits established by regulatory authorities [7].
A number of isolates capable of carrying out some form of degradation of pesticide have been isolated from soils and several fungi are have been isolated and studied, including Aspergillus niger [8], Fusarium graminearum [9], Mucor ramannianus [10] and Gliocladium sp. [11]. Recently, a strain of Trichoderma harzianum has been shown to degrade carbofuran [12] and organochlorines through an oxidative system [13].
Low dose of ionizing radiation on microorganisms is responsible of accelerated enzyme activity [14]. The lowest dose of gamma irradiation (1 MCi for 10 min) enhanced three isolates of Aspergillus niger, investigated to produce more biomass and polygalactronase, pectinmethylglacturonase, cellulase and protease [15]. Trichoderma harzianum, T. viride and T. knoingii irradiated with 0.5 KGy dosage resulted in the highest percentage of pathogen growth reduction by producing highly active exo-enzymes [16]. The two thermophilic isolates, Streptomyces albaduncus and S. erythogresius, were exposed to increasing doses of gamma radiation up to 5 KGy. All radiation did not affect the physiological properties, but relativity higher doses enhanced the utilization of carbon sources and increased their sodium chloride tolerance from 8 to 10%. Dose level of 2 KGy enhanced the antimicrobial activity of both isolates, either at first or second generation against bacteria, moulds and yeasts among them [17]. The low doses of gamma ray (10 and 20 Gy) significantly increased the alcohol-dehydrogenase enzyme activity of Saccharomyces cerevisiae [18].
The present work aimed to apply gamma radiation on Trichoderma spp, and to enhance effective hydrolytic enzymes in their bio-control abilities for biodegradation of oxaml pesticides. Low dose of gamma radiation used to enhancement T. viride and T. harzianum. Several successful attempts had been made to increase the bio-control potential of Trichoderma spp by exposing them to gamma radiation.
Materials and Methods
Soil sampling and characterization
Soil sample were collected from 10 different sub-samples and taken from the areas of 25 m2, (0-20 cm) depth, from heavy clay soil had a previous history of treatment with Oxamyl in the last 10 years at field located in El-Fayoum governorate, Egypt.
Detailed physical and chemical properties of the soil are presented in Table 1. In the laboratory, the soil was gently air-dried to the point of soil moisture suitable for sieving. After sieving to a maximum particle size of <2 mm, the soil kept in a plastic bag at 4ºC for 7 days before use.
Chemicals and reagents
Technical grade Oxamyl (99.1% purity) was purchased from Sigma Aldrich Co., Nasr city, Egypt. All other chemicals and solvents were ultra pure grade and obtained from El-Gomhouria CO. for Trading Chemicals and Medical Appliances, Egypt.

Chemical structure of Oxamyl (Methyl 2-(dimethylamino)-N- [(methylamino) carbonyl] oxy]-2-oxoethanimidothioate).
Enrichment procedure and isolation of microorganisms
Soil contamination: Prepared soil (200 g) was supplemented with Oxamyl at concentration of 50 mg/kg soil, introduced in a form of methanol solution. After mixing and solvent evaporation, the soil was incubated in the dark at 30 ± 1ºC, in a thermostatic chamber for 90 days. The water content of the soil was adjusted to 50%. Throughout the incubation period, water losses exceeding 5% of the initial values were compensated by the addition of deionized water. After 30 and 60 days of incubation, the soil was contaminated again with the same dosage of Oxamyl
Identification of isolates: The pure isolated fungi were identified according to the most documented keys in fungi identification [19,20]. The morphological identification of isolated fungal strains is based on the morphology of the fungal culture colony or hyphae and the characteristics of spores.
Exposure of T. harzianum, T. viride to gamma radiation
The most effective Oxamyl degrading fungi (Trichoderma spp., including T. harzianum, T. viride) selected and exposed to different doses of gamma radiation. Slants of 7 days old culture were irradiated with doses of 0.0, 0.02; 0.05; 0.1; 0.25; 0.5; 1.0; 2.0 and 5.0 KGy, and three replicates were used for each dose. Radiation treatments were carried out at Atomic Energy Authority, Abu-Zabal at dose rate of Egypt's Mega-gamma-1 type, J 6600-Cobalt-60 Irradiator.
Chemical analyses
Extraction and purification of oxamyl: Oxamyl was analyzed by high performance liquid chromatography (HPLC) at Atomic Energy Authority, Abu-Zabal, Egypt. In order to extract Oxamyl from the soil and liquid phases, the soil was slurry centrifuged at 6000 rpm at 25ºC for 15 min to separate the liquid from the soil. The liquid phase was filtered through cellulose acetate paper (Whatman- number 1, England), prior to the liquid–liquid partitioning extraction procedure. Briefly, 2 mL of methanol were added to 2 mL of liquid sample, and then the mixture was sonicated twice for 10 min on a 50/60 voltage cycle. After sonication, Oxamyl was extracted in a separation funnel with dichloromethane. For the method of high-performance liquid chromatography (HPLC), the supernatant was dissolved in the same volume of pure grade methanol and filtrated by membrane filters (0.45 μm). An aliquot of the residue in a 20 μL sample size was injected into a HPLC. The analytical column was Zorbax SB-C18 column (250×4.6 mm, 5 μm), and the solutes were detected using PDA detector with gradient UV-VIS detection ranging from 200 to 600 nm. The mobile phase consisted of 70% methanol and 30% water at a flow rate of 1.0 mL min−1.
Data analysis: Data was analyzed by SPSS program Version 11.5.0. The significance of treatments was set at p-value less than or equal to 0.05 by the one-way ANOVA test.
Results and Discussion
The biochemical and genetic basis of microbial degradation has Received date: considerable attention. Several genes/enzymes which provide microorganisms with the ability to degrade organo-pesticides, have been identified and characterized. The ability of these organisms to reduce the concentration of xenobiotics [21] is directly linked to their long-term adaptation to environments, where these compounds exist. Gamma irradiation may be used to enhance the performance of such microorganisms that have the preferred properties, essential for biodegradation. Therefore, gamma irradiation was used to activate several fungi and determine the activities of their growth under this condition, as well be discussed in our investigation.
Isolation and identification of fungi
Fungi were isolated from soil collected from El-Fayoum governorate treated with different concentration of oxamyl (20-300 mg/L). After several tests of culture on synthetic medium containing the Oxamyl, five fungi were selected and tested for their ability to degrade Oxamyl, pesticide. The fungi strains were identified as Trichoderma spp., including T. harzianum, T. viride, Aspergillus niger, Fusarium oxysporum and Penicillium cyclopium (Table 1) (Figures 1-5). The results showed that Trichoderma spp., including T. harzianum and T. viride, reach its maximum growth using oxamyl concentration of 200 and 100 mg/L and yielded 182.0 and 199.2, respectively. On the other hand, Aspergillus niger reach its maximum yield 166.0 with 200 mg/L, while the growth of Fusarium oxysporum and Fusarium oxysporum were weak (Figures 2 and 6). From the above results, Trichoderma spp. used Oxamyl as source of carbon and nitrogen and possesses enzyme(s) which acts on amide and ester bond in Oxamyl. Degradation of oxamyl was 72.5% within 10 days of incubation by T. harzianum strain. While the degradation of oxamyl was 82.05% within 10 days of incubation by T. viride strain, this indicated that the isolates of Trichoderma spp. were potentially useful for oxamyl bioremediation (Table 2) (Figure 7).
| Oxamyl concentration (mg/L) | Dry weight biomass mg/100 ml* | ||||
|---|---|---|---|---|---|
| T. harzianum | T. viride | Aspergillus niger | Fusarium oxysporum | Penicillium cyclopium | |
| 0 (control) | 133.2 ± (0.40414) | 169.0 ± (0.57735) | 154.2 ± (0.46188) | 95.6 ± (0.51961) | 160.6 ± (0.05773) |
| 20 | 168.6 ± (0.28867) | 178.8 ± (0.51961) | 154.6 ± (0.11547) | 121.8 ± (0.46188) | 157.0 ± (0.28867) |
| 50 | 171.2 ± (0.11547) | 185.6 ± (0.057735) | 156.2 ± (0.17320) | 145.8 ± (0.63508) | 151.8 ± (0.11547) |
| 100 | 176.0 ± (0.92376) | 199.2 ± (0.17320) | 159.4 ± (0.69282) | 137.8 ± (0.11547) | 146.0 ± (0.23094) |
| 200 | 182.0 ± (0.28867) | 175.0 ± (0.40414) | 166.0 ± (0.28867) | 120.2 ± (0.86602) | 141.6 ± (0.80829) |
| 250 | 169.3 ± (0.17320) | 160.0 ± (0.63508) | 145.0 ± (0.51961) | 108.7 ± (0.17320) | 122.0 ± (0.40414) |
| 300 | 152.8 ± (0.11547) | 149.1 ± (0.51961) | 132.0 ± (0.92376) | 96.2 ± (0.40414) | 105.8 ± (0.17320) |
* The values are the means of three replicates with the standard error (in parentheses) which was within 5% of the mean.
Table 1: Effect of oxamyl on the dry weight biomass of isolated fungi in MSM containing different concentrations of oxamyl within 7 days of incubation.
| Fungal strain | Time of incubation ( d ) | Oxamyl control | Oxamyl inoculation | Oxamyl loss (%) |
|---|---|---|---|---|
| T. harzianum | 1 | 198.0 | 175.9 | 12.05 |
| 2 | 196.2 | 148.6 | 25.7 | |
| 3 | 193.2 | 129.0 | 35.5 | |
| 4 | 190.3 | 111.0 | 44.5 | |
| 5 | 189.3 | 101.2 | 49.4 | |
| 6 | 184.9 | 90.6 | 54.7 | |
| 7 | 178.6 | 81.9 | 59.05 | |
| 8 | 172.1 | 72.0 | 64 | |
| 9 | 167.2 | 64.0 | 68 | |
| 10 | 160.0 | 55.0 | 72.5 | |
| T. viride | 1 | 198.0 | 181.8 | 9.1 |
| 2 | 196.2 | 168.2 | 15.9 | |
| 3 | 193.2 | 142.0 | 29 | |
| 4 | 190.3 | 122.2 | 38.9 | |
| 5 | 189.3 | 95.7 | 52.15 | |
| 6 | 184.9 | 76.5 | 61.75 | |
| 7 | 178.6 | 61.0 | 69.5 | |
| 8 | 172.1 | 52.1 | 73.95 | |
| 9 | 167.2 | 44.2 | 77.9 | |
| 10 | 160.0 | 35.9 | 82.05 |
Table 2: Biodegradation of oxamyl (200 mg L-1) in mineral salt medium by Trichoderma spp.
These results agree with those of Rajagopal et al. [22], who isolated Bacillus sp., Micrococcus sp., Arthrobacter sp. and Azospirillum sp. capable of using pesticides as source of carbon and nitrogen. This increase in the biomass of the culture with Oxamyl could be explained by the fact that this product constitutes, an additional carbon and nitrogen contribution, which allows the synthesis of new secondary metabolites favoring the production of microbial biomass, and in consequence, support a faster use of Oxamyl. The increase in biomass (mycelial dry weight) was reported when T. viride strain incubated with pesticides [12]. Therefore, Trichoderma spp have been selected for enhancement by gamma radiation for better biodegradation of oxamyl pesticide.
Effect of gamma radiation on Trichoderma spp
Results in Table 3 and Figures 8 and 9 indicated the effect of different gamma-radiation doses 0.0, 0.02; 0.05; 0.1; 0.25; 0.5; 1.0; 2.0 and 5.0 KGy, on biomass of Trichoderma spp., as well as T. viride grown on MSM with oxamyl at concentration of 200 mg L-1 within 7 days of incubation. The biomass of Trichoderma spp strain were increased and reached its maximum at 250 Gy by 21.97% and 40.0% when using Trichoderma spp., as well as T. viride, respectively. As a general trend, the gamma radiation over than 0.25 Kg reduce the growth of T. spp by 50.27% and 38.13% using Trichoderma spp., as well as T. viride, respectively. Previous studies have shown that relatively low dose of ionizing radiation on microorganisms is responsible of accelerated enzyme activity [14]. The low doses of gamma ray (10 and 20 Gy) significantly increased the alcohol-dehydrogenase enzyme activity of Saccharomyces cerevisiae [18]. Trichoderma harzianum, T. viride and T. knoingii irradiated with 0.5 KGy dosage resulted in the highest percentage of pathogen growth reduction by producing highly active exo-enzymes (cellulosae and chitinase isoenzymes), as confirmed by Haggag and Mohamed [16]. These results are in agreed with stated that growth of T. viride was increased at 0.5 KGy of gamma-radiation. Mycelial dry weight increased in isolates of Aspergillus tamaru, A. flavus and A. niveus, when exposed to gamma-irradiation doses of 0.2 and 0.5 KGy [23]. Previous studies have shown that relatively low dose of ionizing radiation on microorganisms is responsible of accelerated enzyme activity [14]. The low doses of gamma ray (10 and 20 Gy) significantly increased the alcohol-dehydrogenase enzyme activity of Saccharomyces cerevisiae [18]. Trichoderma harzianum, T. viride and T. knoingii irradiated with 0.5 KGy dosage resulted in the highest percentage of pathogen growth reduction by producing highly active exo-enzymes. The results showed that Trichoderma sp. presented a good growth in the presence of DDD and 21% of the pesticide was degraded. In the experiments where DDD was added after 5 days of Trichoderma sp. growth, and with the addition of H2O2, the total biodegradation occurred [24]. Haggag and Mohamed [16] found that mutagenesis of three Trichoderma species by gamma irradiation exhibited high capabilities to produce efficient antibiotics, enzymes and phenols. On the other hand The tested UV-induced mutants were higher in their production of enzymes (cellulases, chitinases and β-1,3- glucanases) than their parental wild type strain (T. viride). Cellulase was the greatest enzyme production by the tested T. viride strains, followed by β-1,3-glucanase then chitinase. Therefore, the enhancement of Trichoderma spp by gamma radiation induce the activation of the main enzymes cellulases, chitinases and β-1,3-glucanases, which depend mainly on the dose of radiation [25]. The enzyme cellulase, a multi enzyme complex made up of several proteins, catalyzes the conversion of cellulose to glucose in an enzymatic hydrolysis. This agrees with previous reports that the amylolytic potential of T. viride was increased at 0.5 KGy of gamma-radiation [26]. Trichoderma harzianum, T. viride and T. knoingii irradiated with 0.5 KGy dosage resulted in the highest percentage of pathogen growth reduction by producing highly active exo-enzymes. Therefore, Trichoderma spp. mutants were effective in reducing the pathogen growth in rhizophere soil, as compared to the wild type strains.
| Gamma irradiation dose (Gy) | Mycelial dry weight (mg/100 ml)* | |||
|---|---|---|---|---|
| T. harzianum | T. viride | |||
| Growth mg/100 ml | % of Change | Growth mg/100 ml | % of Change | |
| 0 | 182.0 ± (0.057735) | 0.0 | 165.0 ± (0.57735) | 0.0 |
| 20 | 198.5 ± (0.02886) | 9.07 | 174.0 ± (0.14433) | 5.45 |
| 50 | 204.0 ± (0.37527) | 12.08 | 189.1 ± (0.23094) | 14.60 |
| 100 | 217.8 ± (0.23094) | 19.67 | 209.5 ± (0.40414) | 26.96 |
| 250 | 222.0 ± (0.40414) | 21.97 | 231.0 ± (0.51961) | 40.0 |
| 500 | 175.2 ± (0.23094) | -3.74 | 151.0 ± (0.40414) | -8.84 |
| 1000 | 129.6 ± (0.17320) | -28.79 | 129.0 ± (0.46188) | -21.81 |
| 2000 | 108.0 ± (0.63508) | -59.34 | 119.0 ± (0.11547) | -27.87 |
| 5000 | 91.50 ± (0.11547) | -50.27 | 102.0 ± (0.28867) | -38.13 |
*The values are the means of three replicates with the standard error (in parentheses) which was within 5% of the mean.
Table 3: Mycelial dry weight (mg/100 ml) of gamma irradiated Trichoderma spp. grown on MSM with 200 mg L-1 of oxamyl at 30°C for 7 days of incubation.
From the results above, Trichoderma strains is attributable to increase biodegradation of the oxymyl pesticide according to one or more complex mechanisms, including nutrient competition, antibiosis, the activity of cell wall-lytic enzymes, induction of systemic resistance and increased plant nutrient availability, as confirmed by Ene and Alexandru [27].
Conclusion
The proposal that our enhancement Trichoderma spp. will involve in the biodegradation of oxamyl pesticides well be belongs to produce of several active enzymes by the two spp of Trichoderma, as confirmed by fungi of Aspergillus niger and Fusarium graminearum [9]. Data in this work indicate the possibility of applying gamma-radiation doses to increase oxamyl degradation by enhancement T. harzianum and T. viride with low dose gamma radiation. An enrichment procedure allowed isolating of two effective fungal strains belonging to T. harzianum and T. viride, that may participate in efficient degradation of the oxamyl. Obtained results have implicated for the development of a bioremediation strategy of oxamyl-polluted soils. However, use of pesticide-degrading microbial systems for removal of pesticide compounds from the contaminated sites requires an understanding of ecological requirements of degrading strains. There is a need for further research on the biochemical and genetic aspects of oxamyl degradation by the isolated fungi. Therefore, this point needs further investigation to study the activity of enzymes needed to degrade oxamyl to its main metabolite and further biodegradable products. In the future, it could even apply Trichoderma spp. directly under special condition or synthetize these enzyme and applied in the field for biodegradation of oxamyl pesticides to clean environments from pollutants.
Acknowledgements
This work was supported by Scientists Next Generation Program, Academy of Scientific Research and Technology, Egypt, and Faculty of Agriculture Biochemistry Department, Cairo University.
References
- Parekh S, Vinci VA, Strobel RJ (2000) Improvement of microbial strains and fermentation processes. Appl Microbiol Biotechnol 54: 287-301.
- Kaufman DD (1987) Accelerated biodegradation of pesticides in soil and its effect on pesticide efficacy. Proc Br Crop Prot Conf Weeds 2: 515-522.
- Negro CL, Senkman LE, Collins PA (2011) Metabolic responses of pleustonic and burrowing freshwater crabs exposed to endosulfan. Fresenius Environ Bull 21.
- Afify AMR, El-Beltagi HS (2011) Effect of the insecticide cyanophos on liver function in adult male rats. Fresenius Environ Bull 20: 1084-1088.
- WHO (World Health Organization) (1986) Organophosphorus Insecticides: A General Introduction. Environmental Health Criteria 63, Geneva. Wei JC (1979) Handbook of Fungi Identification. Technology Press, Shanghai, China.
- Chapalamadugu S, Chaudhry GR (1992) Microbiological and biotechnological aspects of metabolism of carbamates and organophosphates. Crit Rev Biotechnol 12: 357-389.
- Vidali M (2001) Bioremediation. An overview. Pure Appl Chem 73: 1163-1172.
- Zhang Q, Liu Y, Liu YH (2003) Purification and characterization of a novel carbaryl hydrolase from Aspergillus niger PY168. FEMS Microbiol Lett 228: 39-44.
- Salama AK (1998) Metabolism of carbofuran by Aspergillus niger and Fusarium graminearum. J Environ Sci Health B 33: 253-266.
- Seo J, Jeon J, Kim SD, Kang S, Han J, et al. (2007) Fungal biodegradation of carbofuran and carbofuran phenol by the fungus Mucor ramannianus: identification of metabolites. Water Sci Technol 55: 163-167.
- Slaoui M, Ouhssine M, Berny E, El-Yachioui M (2007) Biodegradation of the carbofuran by a fungus isolated from treated soil. Afr J Biotechnol 6: 419-423.
- Wootton MA, Kremer RJ, Keaster AJ (1993) Effects of carbofuran and the corn rhizosphere on growth of soil microorganisms. Bull Environ Contam Toxicol 50: 49-56.
- Katayama A, Matsumura F (2009) Degradation of organochlorine pesticides, particularly endosulfan, by Trichoderma harzianum. Environl Toxicol Chem12: 1059-1065.
- Chakravarty B, Sen S (2001) Enhancement of regeneration potential and variability by gamma-irradiation in cultured cells of Scilla indica. Biol Plant 44: 189-193.
- Gherbawy YA (1998) Effect of gamma irradiation on the production of cell wall degrading enzymes by Aspergillus niger. Int J Food Microbiol 40: 127-131.
- Haggag WM, Mohamed HAA (2002) Enhancement of antifungal metabolites production from gamma-rays induced mutants of some Trichodema sp. for control onion white rot disease. Plant Pathol Bull 11: 45-56.
- Moussa LLA, Mansour FA, Serag MS, Abou El-Nour SAM (2005) Effect of gamma radiation on the physiological properties and genetic materials of Streptomyces albaduncus and S. erythogresius. Int J Agri Biol 7: 197-202.
- Ben-Akacha N, Zehlila A, Mejri S, Jerbi T, Gargouri M (2008) Effect of gamma-ray on activity and stability of alcohol-dehydrogenase from Saccharomyces cerevisiae. Biochem Eng J 40: 184-188.
- Carmichael JW, Kendrick BW, Conners IL, Lynne S (1980) Genera of hyphomycetes. The University of Alberta, CA, USA.
- Barnett HL, Hunter BB (1998) Illustrated genera of imperfect fungi. APS Press, St. Paul, Minnesota, USA.
- Afify AMR (2009) Biological function of xenobiotics through protein binding and transportation in living cells. Int J Agric Res 5: 562-575.
- Rajagopal BS, Rao VR, Nagendrappa G, Sethunathan N (1984) Metabolism of carbaryl and carbofuran by soil –enrichment and bacterial cultures. Can J Microbiol 30: 1458-1466.
- Younis NA (1999) A comparison study on protease, alpha-amylase and growth of certain fungal strains of Aspergillus sp. After exposure to gamma-rays. Arab J Nucl Sci Appl 32: 257-264.
- Ortega SN, Nitschke M, Mouad AM, Landgraf MD, Rezende MO, et al. (2011) Isolation of Brazilian marine fungi capable of growing on DDD pesticide. Biodegradation 22: 43-50.
- Shafique S, Bajwa R, Shafique S (2009) Cellulase biosynthesis by selected trichoderma species. Pak J Bot 41: 907-916.
- Gbedemah CM, Awafo V (1990) Inter Atomic Energy Agency. Vienna, Austria 149: 77-83.
- Ene M, Alexandru M (2008) Microscopical examination of plant reaction in case of infection with Trichoderma and Mycorrhizal fungi. Roumanian Biotechnol Lett 13: 13-19.
Copyright: © 2013 Afify AEMMR, et al. This is an open-access article distributed under the terms of the Creative Commons Attribution License, which permits unrestricted use, distribution, and reproduction in any medium, provided the original author and source are credited.